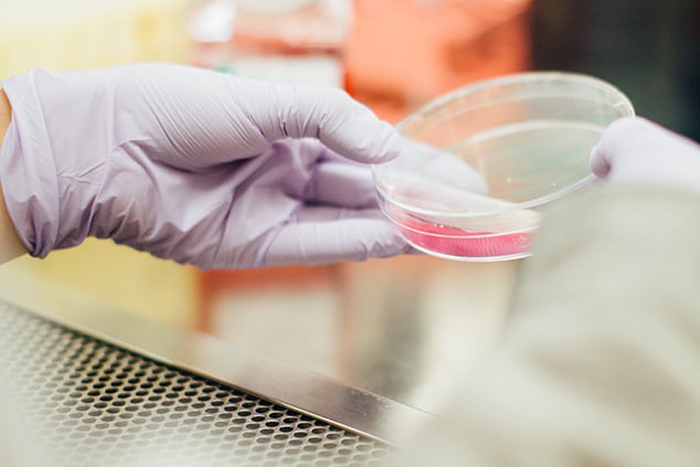

«Биокад» намерен перейти к испытаниям одной из вакцин от коронавируса на людях уже летом. НИИ гриппа готовится к доклиническим исследованиям
В петербургском НИИ гриппа имени Смородинцева и компании «Биокад» рассказали, на каких этапах находятся разработки их вакцин от коронавируса.
НИИ гриппа на данный момент создал прототипы вакцины и намерен приступить к доклиническим исследованиям в июле, рассказал в эфире телеканала «Санкт-Петербург» и.о. директора института Дмитрий Лиознов. Лиознов назвал это «очень неплохим результатом».
Генеральный директор «Биокада» Дмитрий Морозов в том же эфире сообщил, что вакцина, которую компания разрабатывает совместно с новосибирскими центром «Вектор», проходит доклинические испытания на животных. Перейти к этапу с испытаниями на добровольцах разработчики рассчитывают к началу августа.
Среди петербургских разработчиков вакцин одним из лидеров по предположительным срокам запуска производства препарата в правительстве называют Петербургский институт вакцин и сывороток ФМБА России. По словам вице-премьера РФ Татьяны Голиковой, клинические испытания их препарата пройдут с сентября по декабрь, а его производство запустят к декабрю.
Самую первую российскую вакцину власти ожидают получить в сентябре — именно в такой срок намерен запустить промышленное производство препарата НИЦЭМ имени Гамалеи Минздрава РФ. Клинические испытания этой вакцины начинаются в июне.
Ранее «Бумага» рассказывала, что петербургская компания «Биокад» участвует в разработке трех вакцин от коронавируса, которые ВОЗ считает перспективными. Компания рассчитывала в июле перейти к клиническим испытаниям минимум одной своей разработки. Читайте интервью с директором по научному развитию «Биокад» Анной Владимировой о том, как ученые из разных стран обмениваются результатами исследований и почему работа не остановится, даже когда создадут первую вакцину от коронавируса.
Актуальные новости о распространении COVID-19 в городе читайте в рубрике «Бумаги» «Коронавирус в Петербурге».